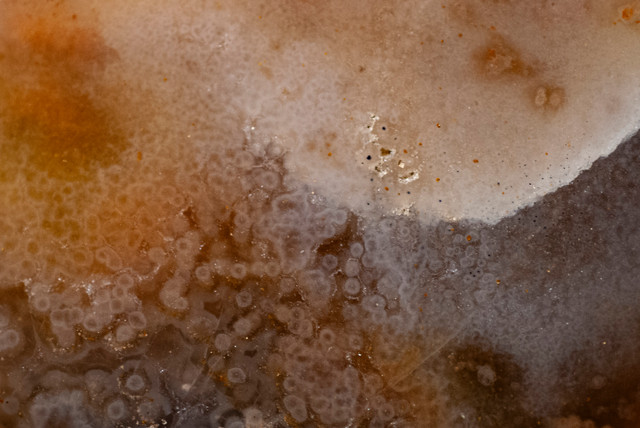

HOME | DD
 TinyWild — Paint Spray
by-nc
TinyWild — Paint Spray
by-nc

#abstract #paint #painting #photography #speckle #splash #splatter #spray #sprayed #streetart #paintsplatter
Published: 2024-02-24 07:00:07 +0000 UTC; Views: 672; Favourites: 20; Downloads: 1
Redirect to original
Description
Detail of a street art painting on a corrugated sheet panel.Détail d’une peinture street art sur panneau de tôle ondulée.